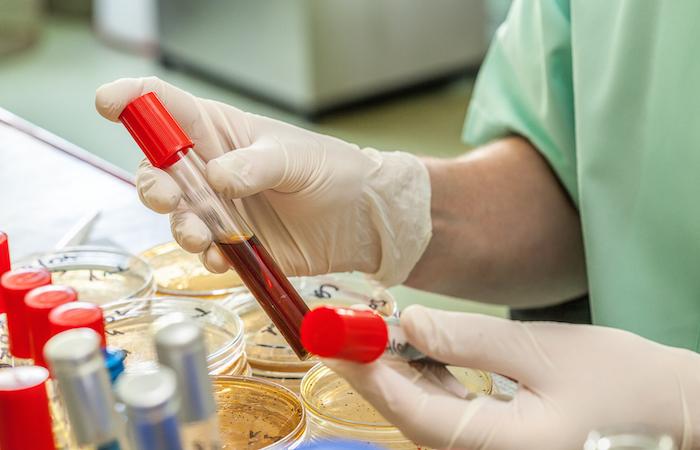

Traquer le VIH jusque dans ses moindres recoins, l’objectif est ambitieux. Les tests actuels n’y parviennent pas. Seule une petite partie des réservoirs du virus est identifiée. Cette étape pourrait être franchie grâce à une équipe de l’université de Pittsburgh (Etats-Unis). Dans Nature Medicine, elle détaille le fonctionnement d’un nouveau test sanguin.
Grâce aux traitements disponibles, le VIH est réduit à des niveaux indétectables dans l’organisme des patients. Sans toutefois atteindre les réservoirs du virus. Les candidats-médicaments et candidats-vaccins ciblent donc ces copies dormantes. Le test TZA, mis au point par les Américains, permet d’identifier celles-ci.
Un tiers moins cher
Lorsque le VIH infecte un organisme hôte, il peut transmettre un ADN viral actif, qui permet aux copies de se répliquer, ou un ADN viral incomplet. Dans le premier, un gène spécifique s’active. C’est justement lui que recherche le test TZA. Avec succès : il repère 70 fois plus de virus dormant chez des personnes sous traitement.
Plus efficace, le test TZA est aussi moins coûteux. Il ne demande qu’une semaine d’analyses, ce qui permet de réduire son coût d’un tiers. Il devrait aussi s’avérer précieux pour les équipes qui travaillent au développement des prochains médicaments contre le VIH. Elles s’attellent maintenant à cibler les réservoirs du virus.
Un test plus précis permettrait de constater l’impact réel des traitements à l’essai. « Ces efforts ne progresseront pas si nous ne disposons pas de tests suffisamment sensibles et pratiques », estime Phalguni Gupta, qui a participé au développement du test TZA.
Une nouvelle cible pour un vaccin thérapeutique
Le Scripps Research Institute (Etats-Unis) fait lui aussi état d’une avancée majeure dans la lutte contre le VIH. Ses chercheurs ont identifié une protéine de surface sur le virus qu’ils sont parvenus à mimer. En imitant la glycoprotéine d’enveloppe, l’équipe est parvenue à fixer une cible pour le système immunitaire, expliquent-ils dans Immunity.
Ces travaux sont réalisés dans l’optique d’un vaccin thérapeutique. Occasion saisie par l’Institut Karolinska (Suède), qui est parvenu à développer un agent immunogène à partir de ces données. Le candidat-vaccin issu de ces travaux est à l’origine d’une réaction du système immunitaire. Celui-ci produit des anticorps qui neutralisent le sous-type C du VIH chez les primates utilisés pour l’expérience.